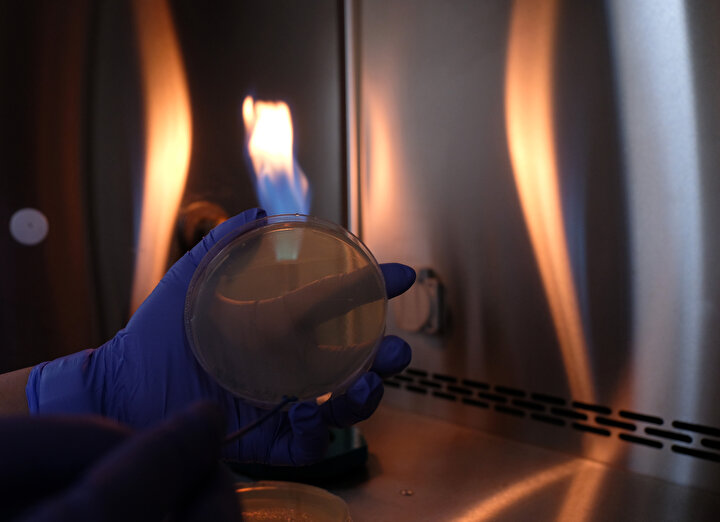

Türkiye'de ilk defa genetik teknolojiyi kullanarak, 'm RNA' temelli koronavirüs aşısı geliştiren merkezlerden biri olan Selçuk Üniversitesi Tıbbi Genetik Bölümü'nde Haziran ayında başlanılan aşı çalışmaları, hayvan deneyleri aşamasına geldi. BioNTech ve Moderna firmalarının geliştirdiği aşıyla aynı özelliği taşıyan aşının gelecek yıl yaz aylarında insanların kullanımına sunulacağını söyleyen aşı projesi yürütücüsü Doç. Dr. Nadir Koçak, "Türkiye'de ilk m RNA çalışmasını biz yapıyoruz. Bu konu üzerinde yoğunlaştık. Türkiye'nin m RNA teknolojisiyle geliştirilmiş ilk aşısı oldu. Şu anda hayvan çalışmaları aşamasına geçmiş bulunmaktayız" dedi.
Türkiye’nin ilk m RNA aşı çalışmasına 15 Haziran’da başladıklarını belirten Tıbbi Genetik Bölümü Ana Bilim Dalı Öğretim Üyesi Doç. Dr. Nadir Koçak şöyle dedi:
"Selçuk Üniversitesi Covid-19 platformunda 2 aşı çalışmasıyla temsil edilmekte. Biz Covid-19 platformu dahilinde m RNA aşı teknolojisine dayalı bir çalışma yapıyoruz. Bu m RNA teknolojisi, dünyada da yeni bir teknoloji. Yaklaşık 4-5 yıllık geçmişi var.
Bizim aslında ekip olarak daha önceden kanser aşıları üzerinde ilgimiz vardı. Özellikle bu yönde okumalar ve çalışmalar içerisindeydik. Biz ekip olarak aslında bu süreçte vicdanen bu yönde birtakım çalışmalar içerisine girme zorunluluğunu kendimizde hissettik ve bu yönde bir proje geliştirme süreci içerisine girdik. TÜBİTAK projemizi çok kısa süre içerisinde kabul etti.
Fakat Covid-19 projesinde yer alan aşı grupları içerisinde en geç başlayan biz olduk, Haziran 15’te çalışmalara başladık. Türkiye’de ilk m RNA çalışmasını biz yapıyoruz. m RNA teknolojisi dünyada 3’üncü aşı teknolojisi olarak tanımlanıyor."
MRNA temelli koronaviris açı çalışmasını anlatan Doç. Dr. Nadir Koçak, "3’üncü jenerasyon aşı teknolojisi bu. MRNA’yı oluşturuyoruz. Sonra mRNA’yı bireylere kas yoluyla uyguluyoruz. Bu m RNA hücrelere gidiyor, hücrede sitoplazmaya gidiyor. Orada ribozomlar tarafından virüsün proteinine dönüştürülüyor. Bu proteinler meydana geldiği için bağışıklık hücrelerimiz bunları tanıyor ve antikor oluşturuyor. RNA’lar DNA’dan genler var, DNA’lar RNA’lara dönüştürlüyor. RNA’lar x geninin RNA'sı oluyor. Hücrede sitoplazmaya giriyor. Sitoplazma da ribozomlarda proteinlere dönüştürülüyor. Bizim hücrelerde oluşan süreci taklit ediyor. Protein üretim teknolojisi de diyebiliriz. Buna sentetik biyoloji de diyoruz" dedi.
Dünyanın önde gelen firmaları BioNTech ve Moderna’yı takip ederek, sürekli projelerini geliştirdiklerini, bunun sonucunda da 4 aşı prototipi oluşturduklarını söyleyen Doç. Dr. Koçak şöyle konuştu:
"3 ay boyunca bu konu üzerinde yoğunlaştık. Hemen arkasından kendi m RNA’mızı dünyada da önde gelen grupları da takip ederek, etkinlik oranı yüksek bunun yanında istediğimiz cevabı alabilecek şekilde dizayn etmeye çalıştık ve bu süre içerisinde kendi aşımızı dizayn ettik. Yakın zamanda da kendi laboratuvarımızda sentezledik. Türkiye’nin m RNA teknolojisiyle geliştirilmiş ilk aşısı oldu. Ve biz şu anda hayvan çalışmaları aşamasına geçmiş bulunmaktayız. 2 ay içerisinde bu süreci tamamlamayı planlıyoruz.
Daha sonra da insan üzerinde çalışmayı planlıyoruz. Bizim şu anda ön görümüz yaz ayı içerisinde insanlara uygulanabilir hale getirmek. Fakat biz alternatifli olarak gitmeye çalışıyoruz. Bu süre içerisinde protokolleri oturtup, bu konuda eksikliklerimizi tamamladıktan sonra arka arkaya 3 yeni dizaynlar oluşturduk. 3 tane dizaynın da 1 ay içerisinde sentezlerini tamamlamayı planlıyoruz. Bu sentezleri planladıktan sonra yaklaşık 4 tane prototip aşıları hayvanlara uygulamaya başlayacağız.
Burada etkinliği yüksek bir aşıyla yürümeyi bundan sonraki süreci onunla götürmeyi planlıyoruz. Çünkü aşıda en önemli şeylerden birisi belli bir etkinliği yakalamak. Bizim takip ettiğimiz BioNTech ve Moderna gibi ekiplerin bu konuda yüzde 90- 95 civarında bir etkinliği yakalaması bizi sevindirdi. Biz de süreç içerisinde aşımızı sürekli modifiye ettik bu etkinliği yakalayabilmek için."
Aşının yakın zamanda hayvan deneylerinde kullanılacağını belirten Doç. Dr. Koçak, "Aşılardan bir tanesi hayvanlara uygulanmaya hazır. 1 ay sonra diğer üç tanesinin de eklenmesiyle 4 tanesini de hayvanlara uygulamaya başlayacağız. Bir tanesi için 10 gün içerisinde başlayacağız. Bu süre içerisinde diğer aşıları da uyguladıktan sonra en etkili olanla yolumuza devam etmeyi planlıyoruz. Bizim planımız yaz ayları. Yaz aylarında insanlara uygulanabilecek düzeye getirmeyi planlıyoruz. Yaz ortalarında süreç istediğimiz gibi tamamlanırsa, insanlara uygulamaya başlamış olacağız" dedi.
Aşı çalışmalarında fedakarlıklarla dolu bir süreç yaşandığını söyleyen Doç. Dr. Nadir Koçak, "Arkadaşlar çok büyük fedakarlıklarla çalışıyorlar. Anadolu’nun çeşitli üniversitelerinden hocalarımız bu çalışmalar içerisinde yer alıyor. Bunun yanında yüksek lisans öğrencilerimiz, uzmanlık öğrencilerimiz de çalışmanın içerisindeler. Hepsi fedakarlık içerisinde, günde 4 saat uykuyla çalışıyorlar. Hafta sonları hepsi burada. Buranın ışığı hemen hemen hiç sönmedi diyebilirim. Bizim ekibimizin hemen, hemen yarısı virüse yakalandı. Bir pandemi hastanesinde çalışmalarımızı sürdürüyoruz. Arkadaşlar hep fedakarlıklar gösterdi. Hatta virüse yakalandıkları zaman bile bizi arayıp ‘hocam iyi hissediyorum ben gelemez miyim? diyen arkadaşlar oldu. ‘Gelsem de sizden uzakta çalışsam’ diyenler oldu. Biz burada projemizde çalışan enfeksiyon hastalıklarında çalışan hocalarımızla danışarak süreci devam ettirdik. Bazen içimiz sızlayarak çalışmaları sınırlamak zorunda kaldığımız dönemlerimiz de oldu" diye konuştu.